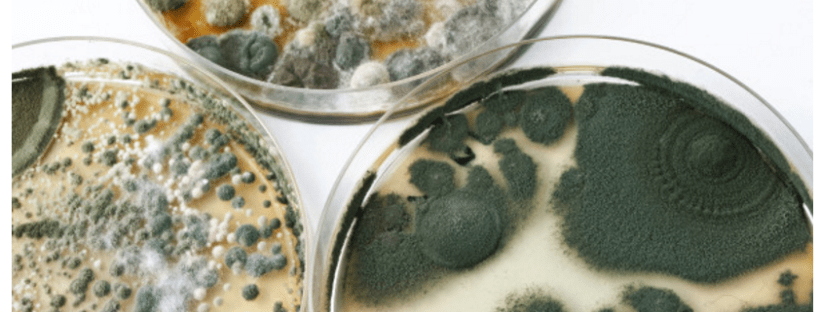

Ta pojem vključuje naslednje dejavnike, ki jih moramo upoštevati:
ŽIVILA
Prehrana je predvsem namenjena zadostni preskrbi telesa z vitamini, minerali, mikroelementi in balastnimi snovmi. Beseda živilo je izpeljanka in pomeni življenjsko snov. Oglejmo si našo prehrano z vidika pojma življenjske snovi. Denaturirana, mrtva živila, torej hitra hrana in “junk food”, s tega vidika niso življenjska snov. Posebno škodljiva je hrana, ki je pripravljena v mikrovalovni pečici, saj je popolnoma mrtva. Namesto da bi prinašala energijo, jo telo celo porablja za razgradnjo mrtve hrane. Redna uporaba mikrovalovne pečice neizbežno vodi k nastanku rakavih obolenj.
V Angliji so opravili zelo zanimivo raziskavo z mačkami, ki ponazarja komaj razvidno, vendar elementarno razliko med količino in kakovostjo. Poskusne mačke so lahko izbirale med različnimi vrstami hrane, dobile so jo v zadostni količini, prav tako tudi vodo. Pazili so le, da so vso hrano in vodo pred hranjenjem na kratko (10 sekund) pogreli v mikrovalovni pečici. Rezultati raziskave so bili šokantni, saj so vse živali po treh tednih poginile zaradi podhranjenosti, čeprav so se ves čas prenajedale.
Naslednji primer katastrofalnega učinka mikrovalovnega sevanja je jabolko. Čeprav je jabolko pogosto kiselkastega okusa, v naši presnovi deluje bazično. Vsebuje organske in mineralne sestavine ter vitamine, ki so zelo ugodni za naš organizem, saj jih lahko v celoti izkoristi.
Zrelo jabolko je torej popoln nosilec živega.
Če ga postavimo za 10 sekund v mikrovalovno pečico, je sicer še vedno podobno jabolku v kemičnem in fizikalnem smislu (spremenjen je le njegov oscilacijski spekter), vendar je s segrevanjem postalo nekaj povsem drugega.
Že po desetih sekundah v mikrovalovni pečici od jabolka (v biofizikalnem smislu) ne preostane nič.
Biofizikalno je jabolko mrtvo, ker ne vsebuje nobene žive strukture več. Postane mrtva snov. In ne samo to. Obremenjuje nas tudi biokemično, saj na našo presnovo ne deluje več bazično, temveč zelo kislo, saj so organski minerali v desetih sekundah postali anorganski. Zato iz semena takšnega jabolka tudi ni več mogoče vzgojiti jablane.
Ta poskus močno spominja na modrost Indijancev, ki so že pred 350 leti prerokovali, da bodo belci nekega dne prišli do točke, ko bodo sicer imeli polne krožnike, pa vendar ničesar, kar bi lahko jedli.
Če opazujemo trenutne razmere ob razvijanju “junk food” družbe, potem smo pravzaprav do te točke že prišli. Kako hranljiva in kakovostna je hrana, ki jo uživamo, in voda, ki jo pijemo? Ali še lahko govorimo o živilih? O sredstvu, ki posreduje življenje? Vse denaturirano (prečiščeno, toplotno obdelano) je mrtvo. Če uničimo in umorimo živilo, potem ni več živi posrednik življenja. Prav tako ne prenaša informacije življenja, kot tako pa ne more “nagovoriti” našega informacijskega sistema. Elektromagnetno nihanje mrtvega jabolka, ki smo ga uničili v mikrovalovni pečici, ne posreduje telesu nobene pozitivne energije. Naš prebavni sistem ga sicer biokemično predela, vendar za to porablja energijo. Ne dobimo energije (informacije) iz živila, ne moremo se več odzvati, posledica pa je, da ne pride do nobene resonance med živilom in telesom. Če živila še razpolagajo z živimi strukturami, lahko dajo energijo in žive, vitalne informacije. Zdajšnji denaturirajoči proizvodni in predelovalni postopki živilu odvzamejo vsakršno življenje.
Zdrav življenjski slog in zdravo prehranjevanje seveda ne pomenita, da se odpovemo vsem užitkom. Cilj celostnega zdravljenja ni, da posameznik postane podložni apostol zdravja, upoštevati moramo tudi individualne danosti in se ustrezno prilagoditi.

ALERGIJE NA ŽIVILA
Najpogostejši prikrit vzrok kroničnih bolezni so alergije na živila. Težava, ki se pri teh alergijah pojavi, je v tem, da je odziv nanje, zlasti pri alergiji na osnovna živila, povsem drugačen kot pri drugih oblikah alergij (alergijah tipa I), denimo pri senenem nahodu. Telo reagira na prehranski alergen s časovnim zamikom več ur ali celo dni (alergija tipa IV). Medtem ko pride na primer pri senenem nahodu neposredno po stiku z alergenom do takojšnje alergijske reakcije (kihanje, kašljanje, srbečica v očeh, srbenje kože …), reakcija na prehranski alergen poteka povsem neopazno ali pa se pokažejo simptomi, ki sprva ne kažejo, da gre za alergijo na hrano, kot so denimo blaga bolečina v trebuhu, vetrovi, zabuhlost, slabo počutje, potrtost ali drugi splošni simptomi. Pogosto so prisotne določene bolezni (na primer atopični dermatitis, luskavica psoriaza, revmatoidne težave), ki jih sprva sploh ne povezujemo z alergijami na hrano. Dejansko pa v telesu nastane alergijska reakcija, ki se ponovi pri vsakokratnem vnosu alergena v telo, in vitalna življenjska energija se stalno porablja v procesu obrambnega odziva.
Alergije na živila povzročajo različne bolezni, med njimi migreno, kronična oziroma vedno znova ponavljajoča se vnetja mehurja, draženje kože, analne fisure, akne vulgaris, bolečinske simptome …
Prehranski alergen določi ustrezno usposobljen bioenergijski terapevt, ki lahko alergen zelo hitro in zanesljivo prepozna z bioenergijskim testom z bioresonančno napravo. Pacient lahko dobi protialergijsko bioresonančno terapijo z velikimi možnostmi za uspeh. Ker trajajo zakasnele alergijske reakcije od nekaj ur do nekaj dni, je telo ob rednem uživanju alergena kronično obremenjeno. Zato se je treba med zdravljenjem držati stroge alergijske diete.

Svinjina
V okviru bioenergijskega celostnega zdravljenja obstaja ena stvar, ki se je moramo strogo držati – prepoved uživanja svinjskega mesa – dosledno med izvajano terapijo in tudi po njej. Odrekanje svinjskemu mesu je pogoj za doseganje in ohranjanje zdravja. S tem mislimo na priljubljene svinjske zrezke in druga živila, ki vsebujejo svinjino (mesni izdelki, šunka, pršut, paštete, klobase, salame, izdelki, ki vsebujejo želatino, svinjska mast …).
Zakaj je popolna prepoved tako nujna? Ker je svinjina za človeka zelo toksična, in to iz več razlogov:
a) Svinjina vsebuje veliko maščob. Svinjsko meso je edino živalsko meso, ki ima maščobe celo v celicah, zato lahko tudi nemastno svinjsko pečenko pečemo v njenem lastnem soku (v maščobi). Pri drugih vrstah mesa je maščoba le v maščobnem tkivu.
b) Svinjina vsebuje veliko holesterola. Človeški organizem ga sicer potrebuje za različne naloge (na primer za gradnjo celičnih membran), vendar se odvečni holesterol kopiči v stenah krvnih žil, kar je vzrok za nastanek ateroskleroze.
c) Svinjina ima zelo neugodno beljakovinsko sestavo in zelo visoko stopnjo razkroja. Hitro začne gniti, pri tem pa nastajajo značilni proizvodi gnitja, ki obremenjujejo črevo, limfo, kri in organe za razstrupljanje in izločanje. Znano je, da se svinjina zelo hitro pokvari. Predstavljajte si kos mlete svinjine pri 37 stopinjah zunanje temperature (telesna temperatura) in visoki vlažnosti (ki je značilna za notranjost črevesa) po približno 48 urah (čas, ko živilo preide v prebavni trakt). Tako ne preseneča, da svinjine na mnogih območjih sveta, kjer prevladujejo visoke temperature, ni mogoče dobiti pri mesarju. V muslimanskih deželah je tako verska prepoved uživanja svinjine zelo praktično utemeljena.
d) Svinjina izrazito negativno učinkuje na sestavo vezivnega tkiva. Njegova naloga je, da povezuje organizem kot celoto. Voda, ki jo sprejema vezivno tkivo, se zadržuje v majhnih molekularnih spojinah, v tako imenovanih mukopolisaharidih, ki večinoma vsebujejo žveplo. Več kot je mukopolisaharidov v vezivnem tkivu, več vode zadrži in toliko bolj je nabreklo. Svinjina vsebuje veliko žvepla, zato se pri uživanju svinjskega mesa precejšnji delež žveplovih spojin nalaga v vezivnem tkivu, ki se tako napolni kot goba z vodo in nabrekne. Zato so kolagen in elastična vlakna močno obremenjeni in hitreje nagnjeni k staranju. Ker se v vsakem delu svinje nahajajo drugačne žveplove spojine, lahko pri nekaterih ljudeh opazimo, katero vrsto svinjine najraje jedo – salo na trebuhu, salo na hrbtni strani, kotlete iz zatilja, šunko. Neželene zaloge sala na zadnjici in stegnu so pogosto povezane z uživanjem svinjskega sala.
e) Sluzne snovi v svinjini se kopičijo tudi v človeških kitah, ligamentih in hrustancu gibalnega aparata. Zato tkivo nabrekne, zasluzi, postane mehko in manj odporno. Posledica je prevelika nategnjenost kit in ligamentov, ki ne morejo več prenašati obremenitev, zato hrustanec degenerira. Slaba vzdržljivost vezi, revma, artritis, artroze in okvare medvretenčnih ploščic so v svojem razvoju pogosto povezani prav s svinjskim mesom.
f) Svinjina je bogata z rastnimi hormoni, ki ne vplivajo zgolj na povečano rast mladostnikov v puberteti, temveč učinkujejo tudi na odrasle. Presežek rastnih hormonov spodbuja na primer vnetja in nabrekanje tkiv. Spodbujajo procese rasti, vplivajo tudi na rast rakavih celic, zato so soodgovorni za nastajanje in širjenje raka.
g) Svinjina vsebuje visoko koncentracijo histamina, najvišjo, ki obstaja pri klavnih živalih. Histamin je zelo učinkovit tkivni hormon, ki je še zlasti aktiven pri agresivnih alergijskih reakcijah. Svinjina tako pospešuje alergijske procese pri senenem nahodu in astmi, pa tudi pri kožnih alergijah, atopičnem dermatitisu … Histamini hkrati spodbujajo vnetne procese, med njimi abscese, ture, črevesna vnetja, vnetja ven, vnetna obolenja kože in tvorbo ekcemov. Pri vsaki stresni obremenitvi se sprosti histamin, kar pospeši negativne pojave stresa in presega njegovo zdravo mero. S tem se poveča nagnjenost k nastanku želodčnih razjed, srčne aritmije, srčnega infarkta …
h) Prašiči so se predvsem zaradi množične reje razvili v zelo obremenjene živali. V preteklosti so bile svinje veliko bolj robustne. Naši stari starši se še spomnijo, da so jih lahko celo jezdili. Hrbet gojenega prašiča danes ni več sposoben prenesti tolikšne teže. Prašiči se odzovejo z visoko stopnjo stresa, visokim izločanjem adrenalina in srčnim infarktom. O tem vedo precej povedati rejci prašičev. Zaradi velike občutljivosti morajo prašiča, ki v grozljivih razmerah množične reje živi svoje kratko življenje, na veliko “pitati” s cepivi in preventivnimi odmerki antibiotikov in pomirjeval. Vse to pa ostane v svinjskem mesu, ki ga uživamo.
Prašič je torej bolna in okužena žival. Zato terapevti naravnega zdravilstva odsvetujemo svojim pacientom uživanje svinjine do konca življenja.

Smrt se skriva v črevesju!
Ta stari rek izvira od starega mojstra medicine Paracelsusa. Dejansko je črevesje eden najpomembnejših organov v našem telesu in ne zgolj zaradi razgrajevanja hranljivih snovi, temveč je odločilen organ za spodbujanje našega imunskega sistema. Določa njegovo “stanje budnosti” in je s površino 400 kvadratnih metrov naš največji organ za razstrupljanje.
Vloga črevesja je neposredno povezana z optimalno sestavo bakterijske flore v njem. Ta bakterijska poselitev zagotavlja njegovo optimalno sposobnost delovanja:
a) Živila se razgradijo s temeljitim žvečenjem in nato zlasti s prebavnimi encimi, ki jih izločajo trebušna slinavka, želodčna sluznica in sluznica tankega črevesa. Optimalno delovanje encimov, ki so v prebavnih sokovih in razgradijo živila v osnovne delce, tako da jih lahko sluznica vsrka, je povezano z normalnimi razmerami v črevesju (tukaj so še posebno moteče obremenitve s prehranskimi alergijami!) in stalnim spodbujanjem tvorbe prebavnih sokov (zlasti jo omejujejo “fast food”, “junk food” in denaturirana – neživa živila). Odločilno vlogo pri optimalni izrabi hranljive kaše pa imajo tudi pripadajoče bakterije, ki so del črevesne flore.
b) Bakterijska poselitev z normalno, zdravo, fiziološko floro v črevesju spodbuja delovanje imunskega sistema. Če v črevesju najdemo patološke bakterije (oziroma disbakterije), se poveča vzdraženost črevesja in hkrati zmanjša delovanje imunskega sistema. Delovanje encimov se zmanjša, spremeni se črevesna flora (še posebej vrednosti pH) in zmanjša se sposobnost predelave hranljive kaše. Posledica je oslabljen imunski sistem: poveča se dovzetnost za okužbe, strupene snovi se slabše predelajo (na primer okoljski strupi), zmanjša se izločanje strupenih snovi, zato se strupi nalagajo v tkivih, ki kot v začaranem krogu spet negativno vplivajo na celotno vitalno energijo.
Danes je tudi v klasični medicini splošno znano, da dober imunski sistem pozitivno vpliva na celotno psihološko počutje. Nemir, slabo razpoloženje, depresije in neugodje pogosto niso nič drugega kot posledica hude obremenitve z napačnimi (patogenimi) bakterijami v črevesni flori.
c) Kot smo že omenili, je črevo naš največji organ za izločanje strupov, saj je površina črevesja okrog 400 kvadratnih metrov. Sposobnost izločanja strupov prek črevesja in končno z blatom iz telesa je vsekakor povezana z budnostjo imunskega sistema in izmenjavo strupenih snovi z normalno fiziološko bakterijsko floro. Če pride do resne disregulacije v črevesju, telo ne more več razstrupljati prek črevesja. Zato se poveča obremenitev drugih organov za razstrupljanje telesa: jeter, žolča, ledvic, pljuč, mehurja in kože. Akutne pojave, kot so na primer akne, ogrci, luščenje kože in tudi nastanek kronično obremenjujočih obolenj ledvic (nefrotični sindrom), je mogoče pripisati pomanjkljivemu razstrupljanju prek črevesja.
Analiza stanja v črevesju je prav tako osrednja naloga terapevta. Saniranje črevesja opravimo z ustreznimi črevesnimi simbionti (probiotičnimi bakterijami) in doslednim izvajanjem diete, ki jo določi terapevt.

Sladkor
Rafinirani, denaturirani beli sladkor ima negativni učinek na normalno črevesno floro, saj se bakterije na njegovo prisotnost odzovejo z zmanjšano rastjo in se bakterijska poselitev spremeni. Tako sproščene površine na črevesni sluznici zasedejo druge bakterije, ki ne spadajo v zdravo črevesje, in sladkor pospešuje fermentacijo in gnitje.
Sanacija črevesja je uspešna le, če sladkor za daljše obdobje dosledno odstranimo iz prehrane, s čimer omogočimo prenovo črevesne flore. To še zlasti velja za rafinirani sladkor (beli in rjavi), pa tudi sladkor v medu, suhem sadju, sadnih sokovih in sirupih. Fruktozo v sadju, torej sadni sladkor v naravni obliki, lahko uživamo, pri večjih težavah pa se moramo za nekaj časa odpovedati tudi sladkemu sadju (na primer bananam, grozdju, figam, ananasu). Umetnemu (sintetičnemu) sladkorju se je bolje izogniti že zaradi morebitnega tveganja pri spodbujanju nastanka raka.
Tudi po sanaciji črevesja priporočamo, da zelo omejite uživanje sladkorja. Pri njegovi presnovi se namreč v telesu porabljajo vitamini in minerali, povzroča tudi nastanek kariesa in močno zakisa telo. Pri obremenjevanju telesa s sladkorjem je zelo pomembno, kako pogosto ga uživamo. Za zajtrk marmelada, po kosilu posladek, popoldan ob kavi piškoti, zvečer še kakšen sladek prigrizek, vmes pa grižljaj čokoladnih rezin. Zmeraj je prisoten sladkor. Tudi pri zmernih količinah sladkorja vodi stalno sladkanje v zaslajevanje črevesne flore in pomeni trajno obremenitev črevesja. Če že grešite, mirno pojejte celo tablico čokolade, potem pa več dni ostanite brez sladkorja. To namreč ne prinaša večjih težav, vsakodnevno večkratno uživanje sladkorja pa povzroči, da se v črevesju razvijejo patološke bakterije in glivice (na primer kandida).
Pomanjkanje prebavnih encimov
Kakšne simptome dobimo zaradi težav pri prebavljanju, je odvisno od tega, katera encimska skupina je oslabljena.
a) Fermentacija (vrenje) se začne zaradi pomanjkanja encimov, ki presnavljajo ogljikove hidrate (kruh, zelenjava, presna hrana …). Če jih encimi ne morejo razgraditi, ogljikovi hidrati preidejo v globlje plasti črevesja, kjer zaradi daljšega zadrževanja nastane alkoholno vrenje. Pri tem nastanejo zelo strupeni alkoholi, kot so etilalkohol, metilalkohol in podobni. Telo te alkohole vsrka in tako preidejo v jetra, kjer se razstrupijo. Vendar pa so kljub temu izjemno strupeni in zelo hitro lahko povzročijo poškodbe jeter. Mnoge okvare jeter velikokrat niso posledica uživanja alkohola v pijačah (pivo, vino …), temveč jih povzročajo alkoholi, ki nastajajo pri vrenju v črevesju. V primerjavi z navadnimi alkoholi je njihova toksičnost dvajsetkrat večja, to pomeni, da je kozarec alkoholov iz vrenja tako škodljiv kot 20 kozarcev čistega žganja. Simptomi kronične obremenitve z vrenjem so bledična koža, rumenkasta beločnica, nezdrava barva obraza, splošna mlahavost, utrujenost, nerazpoloženost, nesposobnost prenašanja večjih obremenitev in motnje koncentracije.
Vrenje v črevesju ima še eno negativno posledico. Bakterijska flora se spremeni toliko, da se lahko razmnožijo patogene (škodljive) bakterije, in težave v črevesju se s tem še povečajo.
b) Če pride do pomanjkanja encimov pri presnovi živalskih beljakovin, se beljakovine pomanjkljivo prebavijo in preidejo v globlje plasti črevesja, kjer se zaradi dolgotrajnega zadrževanja začnejo procesi gnitja (gnilobna dispepsija) Ti procesi so za organizem zelo strupeni. Tudi te proizvode gnitja vsrka telo, kjer učinkujejo zlasti strupeno na jetra in škodljivo na živčni sistem.
Klasični simptomi črevesnega gnitja so šibkost, pomanjkanje koncentracije, pozabljivost, splošno slabo počutje in nerazpoloženost, lahko pa tudi nevrološke bolečine, glavobol, migrena, revmatična obolenja, depresije vseh vrst, kožna obolenja (na primer akne, abscesi) in kronična obolenja ledvic. Tudi pri gnilobni dispepsiji se spremeni črevesna flora in patogene bakterije se lahko nenadzorovano razmnožijo, s čimer se težave s črevesjem še povečujejo.
Naša telesna teža je odvisna od življenjskega sloga. Prevelika in premajhna teža sta za naše telo zelo škodljivi, saj so pri tem prizadeti vsi organi. Premajhna telesna teža je pogosto posledica pomanjkljive razgradnje živil (glej zgoraj) ali pa je povezana s psihičnimi težavami, ki lahko izhajajo prav iz delovanja črevesja (glej vrenje in gnilobni procesi). Nasprotno pa je pri preveliki telesni teži treba shujšati.
Preskrba z vitamini, minerali in mikroelementi
Glavni pogoj za nemoteno delovanje presnove človeka je zadostna preskrba z vitamini, minerali in elementi v sledovih (poimenovani tudi mikroelementi: npr. baker, cink, fluor, jod, kobalt, krom, magnezij, mangan, molibden, selen, vanadij, železo), ki jih telo praviloma pridobi iz živil. Vendar se je njihova kakovost v zadnjem času občutno zmanjšala. Primerjalna raziskava za leti 1986 in 1995 je to nazorno pokazala. Cena za dolgoletno intenzivno poljedelstvo je osiromašenje tal, ki ne vsebujejo več dovolj vitalnih snovi. To ni problematično samo pri klasični pridelavi, temveč tudi v ekološkem kmetijstvu.
Vitamini, minerali in mikroelementi v hranljivi kaši se lahko sprostijo le, če se živila ustrezno razgradijo. Če se to ne zgodi, dodatno dovajanje vitaminov, mineralov in elementov v sledovih ne zadostuje več.
Zelo se je povečala tudi prisotnost okoljskih strupov v živilih. Mnogi vitamini, minerali in mikroelementi reagirajo na okoljske strupe tako, da se nanje vežejo in jih nevtralizirajo, telo jih tako ne more več uporabiti. Zato je pogosto nujno, da povečamo količino vitaminov, mineralov in elementov v sledovih s prehranskimi dodatki.
Katere in kolikšne naj bodo količine zaužitih ortomolekularnih snovi (vitaminov, mineralov, encimov in aminskih kislin), lahko na podlagi bioenergijskega testiranja zelo hitro določi ustrezno usposobljen terapevt, ki zna zdraviti z naravnimi metodami zdravljenja. Pomembno pa je, da so ortomolekularne snovi biološkega izvora in ne kemično pridobljene, ker jih drugače telo ne more izkoristiti (uporabiti).
Vir: Karin Rižner